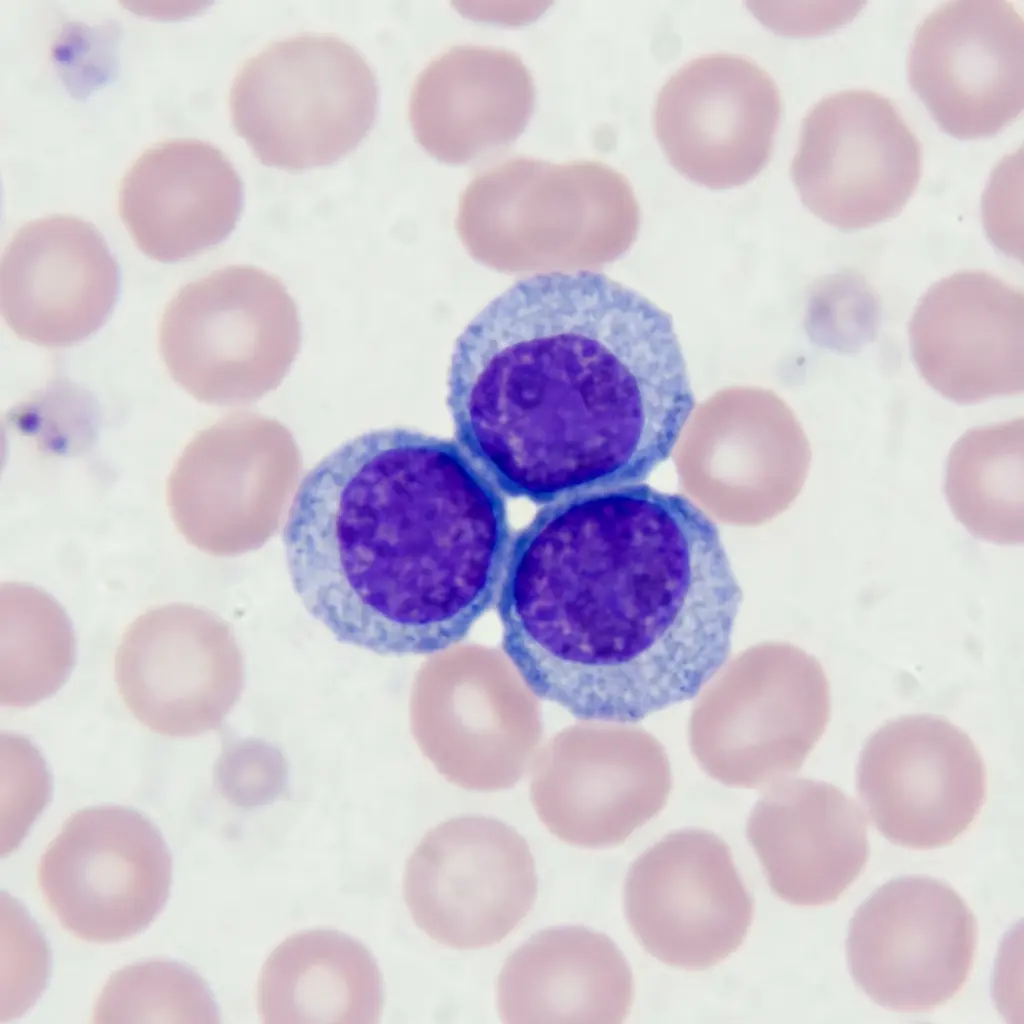
TODO

Erhöhte Basozyten im Blutbild sind oft ein Zufallsbefund, der selten allein eine schwere Krankheit anzeigt. Dieses Phänomen, medizinisch als Basophilie bezeichnet, kann vielfältige Ursachen haben – von einer einfachen Allergie bis hin zu chronischen Entzündungen. In der Schweiz ist es ratsam, den Befund mit der Hausärztin oder dem Hausarzt zu besprechen, um die nächsten Schritte festzulegen.
Dieser Artikel vom Redaktionsteam Gut leben liefert verlässliche und praxisnahe Informationen aus der Schweiz. Die medizinischen Inhalte wurden durch einen erfahrenen Hämatologen überprüft, was höchste Genauigkeit gemäss aktuellem Wissensstand sicherstellt. Hier finden Sie nicht nur Informationen über erhöhte Basozyten und deren Bedeutung, sondern auch konkrete Hinweise zur Befundinterpretation und zu den nächsten diagnostischen Schritten in der Schweiz.
Inhaltsverzeichnis
- Erhöhte Basozyten auf einen Blick: Die wichtigsten Informationen und ein schneller Entscheidungspfad
- Erhöhte Basozyten (Basophilie): Ein Überblick über die häufigsten Ursachen
- Diagnostischer Algorithmus Schritt für Schritt: Welche Untersuchungen sollten nach Erhalt des Befunds durchgeführt werden?
- Alarmsignale: Welcher Basozyten-Wert ist beunruhigend und wann sollte man dringend einen Hämatologen aufsuchen?
- Erweiterte Diagnostik: Basophilen-Aktivierungstest (BAT) und Knochenmarksbiopsie
- Zusammenfassung: Erhöhte Basozyten sind ein Hinweis, keine Diagnose
- Häufig gestellte Fragen (FAQ)

Erhöhte Basozyten im Überblick: Wichtigste Informationen und Entscheidungsweg
Ein erhöhter Basozyten-Spiegel (Basophilie) weist häufig auf eine Allergie, eine chronische Entzündung oder eine Schilddrüsenunterfunktion hin. Der Normwert im Blutbild liegt bei 0–1 % aller Leukozyten, was etwa 100–300 Zellen pro Mikroliter Blut entspricht.
Bei einem erhöhten Befund sollten Sie diesen systematisch abklären. Hier finden Sie den nächsten logischen Schritt:
- Erster Schritt: Sie müssen den Befund zuerst bestätigen lassen. Ein erneutes Blutbild, idealerweise ein manuelles Differentialblutbild, liefert hierzu die genaueren Ergebnisse als die automatische Analyse.
- Basisdiagnostik: Ergänzend können Entzündungsparameter (CRP und BSG), die Schilddrüsenfunktion (TSH) und ein allergologischer IgE-Test sinnvoll sein, um der Ursache auf die Spur zu kommen.
- Wann zum Spezialisten: Ein dauerhaft hoher oder ansteigender Wert, besonders zusammen mit anderen Auffälligkeiten im Blutbild, sollte zeitnah von einem Hämatologen (Spezialist für Blutkrankheiten) abgeklärt werden. In der Schweiz können Sie dafür direkt über Ihren Hausarzt eine Überweisung erhalten.
Was sind Basozyten und welche Rolle spielen sie im Körper?
Basozyten (Basophile Granulozyten) sind die kleinste Untergruppe der weissen Blutkörperchen und wichtige Akteure bei Entzündungs- und allergischen Reaktionen. Sie machen zwar weniger als 1 % der Leukozyten aus, ihre Granula speichern jedoch potente Botenstoffe.
Die gespeicherten Substanzen in den Granula erklären ihre Wirkung im Körper. Die beiden wichtigsten sind:
- Histamin: Bei Freisetzung erweitert es die Blutgefässe und macht sie durchlässiger – das verursacht die typischen Symptome wie Rötung, Schwellung und Juckreiz bei Heuschnupfen oder Nesselsucht.
- Heparin: Dieser natürliche Gerinnungshemmer verhindert eine übermässige Blutgerinnung an der Entzündungsstelle und sorgt so für einen ungehinderten Zustrom anderer Immunzellen.
Neben Allergien sind Basozyten auch an der Abwehr von Parasiten und chronischen Entzündungsprozessen beteiligt. Genau hier passieren in der Praxis viele Fehler: Wegen ihrer geringen absoluten Zahl im Blut können schon kleine Veränderungen zu grossen prozentualen Schwankungen führen. Daher ist eine sorgfältige Interpretation der Basozyten-Werte im Blutbild entscheidend, die stets sowohl den Prozentwert als auch die absolute Zellzahl berücksichtigen muss.

Basophilen-Normen: So interpretierst du Ergebnisse und rechnest Prozentwerte in absolute Werte um
Die klinisch aussagekräftigere Grösse für die Beurteilung von Basophilen ist der absolute Wert in Zellen pro Mikroliter, nicht der prozentuale Anteil. Der prozentuale Wert (BASO %) zeigt nur den Anteil der Basophilen an der Gesamtzahl der weissen Blutkörperchen und liegt bei Erwachsenen normalerweise bei 0–1 %. Der absolute Wert (BASO #) hingegen gibt die tatsächliche Zellzahl an und bewegt sich im Normbereich zwischen etwa 100–300 Zellen/µl.
- Prozentualer Wert (BASO %): Dieser gibt an, welchen Anteil die Basophilen an allen weissen Blutkörperchen (WBC) ausmachen. Der Normbereich für Erwachsene liegt typischerweise bei 0–1 %.
- Absoluter Wert (BASO # oder Zellen/µl): Dies ist die tatsächliche Anzahl Basophilen in einem Mikroliter Blut. Der Normbereich liegt bei etwa 100–300 Zellen/µl.
Der Prozentwert kann in die Irre führen, besonders bei veränderter Gesamtleukozytenzahl. Ist die Gesamtzahl der Leukozyten tief, kann selbst eine normale absolute Basophilenzahl einen hohen Prozentwert ergeben. Umgekehrt kann ein normaler Prozentwert bei einer sehr hohen Leukozytenzahl eine tatsächlich erhöhte Basophilenzahl verdecken.
Wie rechnet man Prozent selbst in einen absoluten Wert um?
Du kannst die Umrechnung mit einer einfachen Formel durchführen, wenn du zwei Werte aus deinem Blutbild kennst: den BASO% und die Gesamtleukozytenzahl (WBC).
Formel: (BASO% / 100) * WBC (in Tsd./µl) * 1’000 = Basophilenanzahl/µl
Die folgende Tabelle aus der Praxis in einem Schweizer Spital zeigt, wie derselbe Prozentwert je nach Gesamtleukozytenzahl eine völlig andere Bedeutung haben kann. Mehr über die Interpretation solcher Blutwerte lesen Sie in unserem Artikel zu Bluttests auf Vitamine und Mineralstoffe.
| BASO Ergebnis (%) | Gesamtleukozytenzahl (WBC) | Berechneter absoluter Wert (Zellen/µl) | Klinische Interpretation |
|---|---|---|---|
| 2 % | 5’000/µl (Norm) | 100/µl | Wert im Normbereich |
| 2 % | 10’000/µl (obere Normgrenze) | 200/µl | Wert im Normbereich |
| 2 % | 15’000/µl (erhöhte WBC) | 300/µl | Wert an der Normgrenze |
| 2 % | 25’000/µl (hohe WBC) | 500/µl | Deutlich erhöhter Wert (Basophilie) |
Wie du siehst, kann ein Ergebnis von 2 % sowohl normal als auch besorgniserregend sein. Daher beurteilen Ärztinnen und Ärzte in der Schweiz den absoluten Wert stets im Kontext des gesamten Blutbildes und der klinischen Symptome.
Erhöhte Basophilen (Basophilie): Die häufigsten Ursachen im Überblick
Eine Basophilie, also ein erhöhter Basophilenspiegel, kann viele Ursachen haben – von harmlosen, vorübergehenden Reaktionen bis hin zu ernsthaften Erkrankungen. Ein erhöhter Wert allein ist kein Grund zur Panik, muss aber im klinischen Kontext bewertet werden.
Häufigste Ursachen für Basophilie:
- Allergien: Dies ist die häufigste Ursache in der Schweizer Praxis. Reaktionen auf Pollen (Heuschnupfen), Hausstaubmilben, Nahrungsmittel oder Kontaktallergene führen zur Aktivierung der Basophilen und Histaminfreisetzung. Die Basophilie geht hier oft mit einem Anstieg der Eosinophilen einher. Mehr darüber haben wir in unserem Artikel über Rekuperation und Luftqualität zur Vermeidung von Allergien beschrieben.
- Endokrinologische Erkrankungen: Insbesondere eine Schilddrüsenunterfunktion (Hypothyreose), inklusive der Hashimoto-Thyreoiditis. Hormonelle Störungen können die Blutbildung beeinflussen.
- Chronische Entzündungen und Autoimmunerkrankungen: Krankheiten wie rheumatoide Arthritis, Colitis ulcerosa oder systemischer Lupus erythematodes können eine chronische Stimulation des Immunsystems und damit der Basophilen verursachen.
- Infektionen: Bestimmte virale Infekte (z.B. Windpocken, Grippe) sowie parasitäre Infektionen können zu einem vorübergehenden Anstieg führen. Detaillierte Informationen zur Diagnostik parasitischer Infektionen finden Sie in unserem Beitrag zu Wurmkur und Diagnostik.
- Myeloproliferative Neoplasien (MPN): Dies ist die schwerwiegendste, aber seltenste Ursachengruppe. Dazu gehören die chronische myeloische Leukämie (CML), die Polycythaemia vera oder die Myelofibrose. Die Basophilie ist hier meist erheblich und geht mit anderen gravierenden Abweichungen im Blutbild einher. Details zur Diagnostik der chronischen myeloischen Leukämie im Zusammenhang mit Basophilen finden sich in den Quellen.
Die folgende Tabelle zeigt einen vereinfachten Vergleich typischer Blutbilder bei verschiedenen klinischen Zuständen, wie sie in der kantonsärztlichen Praxis vorkommen können.
| Parameter | Allergie | Schilddrüsenunterfunktion | Verdacht auf chronische myeloische Leukämie (CML) |
|---|---|---|---|
| Basophilen (BASO) | Leicht oder mässig erhöht | Leicht erhöht | Erheblich erhöht, oft ansteigend |
| Eosinophile (EO) | Oft erhöht | Im Normbereich | Können erhöht sein |
| Leukozyten (WBC) | Normal oder leicht erhöht | Normal | Erheblich erhöht (>20’000/µl) |
| Hämoglobin (HGB) | Normal | Normal oder leicht erniedrigt | Oft erniedrigt (Anämie) |
| Thrombozyten (PLT) | Normal | Normal | Können erhöht, normal oder erniedrigt sein |

Schritt-für-Schritt Diagnostik-Algorithmus: Welche Untersuchungen sind nach Erhalt des Resultats nötig?
Ein erhöhter Basophilenwert (Basophilie) markiert den Beginn der Abklärung und ist noch keine Diagnose. Die folgende schrittweise Vorgehensweise, wie sie auch in Schweizer Hausarztpraxen üblich ist, zeigt Ihnen den strukturierten Weg von der Verifizierung bis zur Spezialdiagnostik.
- Schritt 1: Bestätigung des Resultats und manuelles Blutausstrichpräparat
Jedes auffällige Resultat eines hämatologischen Analyseautomaten muss verifiziert werden. Eine Blutbildwiederholung nach 2–4 Wochen ist der erste Schritt, verbunden mit der Anforderung eines manuellen Blutausstrichs. Bei diesem Verfahren untersucht ein Labordiagnostiker die Zellen direkt unter dem Mikroskop, was eine genauere Beurteilung der Basophilen und den Nachweis von abnormalen, unreifen Zellformen ermöglicht, die der Automat übersehen haben könnte. - Schritt 2: Basis-Laboruntersuchungen
Zeigt sich die Basophilie erneut, ist ein Basis-Laborpaket zur Ursachenfindung angezeigt, das Ihr Hausarzt oder Ihre Hausärztin in der Regel veranlassen kann. In Schweizer Praxen umfasst dies häufig:- CRP und BSG: Marker für einen allgemeinen Entzündungszustand.
- TSH: Zur Basisabklärung der Schilddrüsenfunktion.
- Gesamt-IgE: Ein Hinweis auf eine mögliche allergische Ursache.
- Schritt 3: Gezielte weiterführende Diagnostik
Die Resultate der Basisuntersuchungen sowie Ihre Symptome lenken das weitere Vorgehen. Je nach Verdacht kann Ihr Arzt folgende Tests anordnen:- Allergiepanels für spezifisches IgE: Bei erhöhtem Gesamt-IgE zur Identifikation konkreter Allergene.
- Untersuchungen auf Parasiten: Falls die Symptome darauf hindeuten – denken Sie an Reiserückkehrer.
- Anti-TPO- und Anti-TG-Antikörper: Bei Verdacht auf eine autoimmune Schilddrüsenerkrankung wie Hashimoto-Thyreoiditis.
- Schritt 4: Überweisung zum Hämatologen
Eine anhaltende oder ausgeprägte Basophilie, besonders zusammen mit weiteren Warnzeichen, erfordert eine Überweisung an eine Fachärztin für Hämatologie. Eine rasche Überweisung ist über die kantonale Spitalliste oder die Hausarztpraxis möglich. - Schritt 5: Molekular- und genetische Untersuchungen (beim Hämatologen)
Bei Verdacht auf eine blutbildende Systemerkrankung veranlasst die Hämatologin spezifische genetische Bluttests. Die zwei wichtigsten sind:- Test auf das BCR-ABL1-Gen: Entscheidend für die Bestätigung oder den Ausschluss einer chronischen myeloischen Leukämie (CML).
- Test auf die JAK2-Mutation: Charakteristisch für andere myeloproliferative Neoplasien (MPN) wie die Polycythaemia vera.
Warnsignale: Welcher Basophilenwert ist bedenklich und wann ist ein dringender Termin beim Hämatologen notwendig?
Die absolute Anzahl der Basophilen und begleitende Symptome sind entscheidend für die Dringlichkeit einer weiteren Abklärung. Obwohl viele Ursachen harmlos sind, gibt es klare Warnzeichen, die eine umgehende Vorstellung bei einem Spezialisten erforderlich machen.
Der absolute Wert ist der Schlüsselindikator.
Besonders alarmierend ist ein anhaltender oder wiederholt steigender absoluter Basophilenwert über 500/µl und insbesondere Werte über 1’000/µl. Genau hier entscheidet sich oft, ob eine rasche hämatologische Beurteilung nötig ist.
Liste der Warnsignale (rote Flaggen):
Eine Basophilie, die mit mindestens einem der folgenden Laborbefunde einhergeht, erfordert eine dringende hämatologische Abklärung:
- Deutliche Leukozytose: Die Gesamtzahl der weissen Blutkörperchen (WBC) liegt über 20’000/µl.
- Blutarmut (Anämie): Erniedrigte Hämoglobin- und Hämatokrit-Werte.
- Thrombozytopenie: Verminderte Anzahl der Blutplättchen (PLT).
- Nachweis unreifer Zellformen im Ausstrich: Auftreten von Zellen im Blut, die normalerweise nur im Knochenmark vorkommen (z.B. Blasten, Myelozyten).
- Gleichzeitige Erhöhung anderer Granulozyten: Deutlicher Anstieg der Neutrophilen und/oder Eosinophilen.
Klinische Symptome, die Anlass zur Sorge geben:
Neben den Laborwerten sind auch allgemeine systemische Symptome alarmierend, wie etwa:
- Nächtliches Schwitzen.
- Unerklärlicher Gewichtsverlust (>10% innerhalb von 6 Monaten).
- Chronische, starke Erschöpfung.
- Vergrösserung der Milz, die Sie als Völlegefühl, Druck oder Schmerz im linken Oberbauch wahrnehmen können.
Treten bei Ihnen eine Basophilie zusammen mit einem der oben genannten Symptome oder Auffälligkeiten im Blutbild auf, sollten Sie umgehend eine ärztliche Konsultation – im Zweifelsfall direkt bei einem Hämatologen – suchen. Die Wartezeiten für Facharzttermine können in der Schweiz kantonal variieren, weshalb eine zeitnahe Abklärung wichtig ist.
Fortgeschrittene Diagnostik: Basophilenaktivierungstest (BAT) und Knochenmarksbiopsie
In komplexeren Fällen können Standarduntersuchungen im Kanton Zürich für eine definitive Diagnose unzureichend sein. Dann kommt fortgeschrittene Diagnostik wie der Basophilenaktivierungstest oder eine Knochenmarksbiopsie zum Zug.
Der Basophilenaktivierungstest (BAT) ist eine hochspezialisierte Funktionsanalyse für das Blut. Das Prinzip ist einfach, die Umsetzung aber anspruchsvoll: Dabei werden die Basozyten des Patienten im Reagenzglas (in vitro) bestimmten, verdächtigen Allergenen wie Medikamenten oder Insektengiften ausgesetzt. Die Aktivierung dieser Zellen wird dann unter dem Mikroskop oder mittels Durchflusszytometrie nachgewiesen.
- Anwendung: Spezialisierte Zentren in der Schweiz, etwa an der Unispital Zürich, führen den BAT hauptsächlich in der fortgeschrittenen Allergiediagnostik ein, wenn Standard-Haut- oder Bluttests nicht eindeutig sind – etwa bei Verdacht auf Arzneimittelallergie oder Reaktionen auf Lebensmittelzusatzstoffe.
- Einschränkungen: Der BAT ist eine kostspielige Untersuchung mit begrenzter Verfügbarkeit, die ein hochspezialisiertes Labor erfordert. Genau hier zeigt sich der Nutzen eines gut vernetzten schweizerischen Gesundheitssystems für eine rasche Einweisung.
Die Knochenmarksbiopsie ist eine invasive Untersuchung, die spezialisierten Kliniken wie dem Universitätsspital Basel vorbehalten ist. Sie kommt nur bei starkem Verdacht auf eine hämatologische Erkrankung wie Leukämie zum Einsatz, wenn Blut- und molekulare Untersuchungen eine endgültige Bestätigung erfordern.
- Ziel der Untersuchung: Sie ermöglicht eine direkte Beurteilung der Knochenmarkzellen – der «Fabrik», die Blutzellen produziert. Dies erlaubt die Beurteilung ihrer Morphologie, ihrer Anteile und die Durchführung zytogenetischer Untersuchungen (Chromosomenanalyse).
- Ablauf: Die Prozedur umfasst die Entnahme einer Knochenmarkprobe, meist vom Beckenkamm, mit einer speziellen Nadel (Knochenmarksaspiration und Trepanbiopsie). Sie wird in der Regel ambulant unter lokaler Betäubung durchgeführt.
- Wichtiger Hinweis: Bei Verdacht auf chronisch myeloische Leukämie (CML) reicht für die Diagnosestellung in Schweizer Zentren häufig ein Bluttest auf das BCR-ABL1-Gen aus. Eine Knochenmarksbiopsie ist im Anfangsstadium nicht immer notwendig und dient vor allem der Einschätzung des Krankheitsstadiums. Weitere Informationen zu diesem Thema finden sich in Fachquellen wie Onkopedia.
Zusammenfassung: Erhöhte Basozyten sind ein Signal, keine Diagnose
Erhöhte Basozyten im Blutbild sind ein wichtiges Signal, das stets Beachtung erfordert, aber selten Anlass zur Sorge gibt. Dieser Befund ist keine Diagnose, sondern ein Hinweis für Ihren Arzt oder Ihre Ärztin, der im Kontext aller Untersuchungsergebnisse und Ihrer Krankengeschichte interpretiert werden muss.
Denken Sie daran, dass die Ursache einer Basophilie in der Schweiz oft harmlos und einfach zu behandeln ist, wie etwa eine saisonale Allergie oder eine Schilddrüsenunterfunktion. Der Schlüssel liegt jedoch darin, diesen Befund nie zu ignorieren. Ein systematisches Vorgehen – das Gespräch mit Ihrer Hausärztin, die Wiederholung der Untersuchung und die Durchführung der empfohlenen Diagnostik – ist der beste Weg, die Ursache zu klären und Ihre Ruhe zurückzugewinnen.
Häufig gestellte Fragen (FAQ)
Was sind die Referenzwerte für Basophile und wo liegt der Unterschied zwischen Prozentwert und Absolutzahl?
Die Normalwerte für Basophile betragen 0–1 % aller weissen Blutkörperchen (prozentualer Anteil) oder 100–300 Zellen pro Mikroliter Blut (Absolutwert). Die Absolutzahl ist klinisch aussagekräftiger, weil sie die tatsächliche Zellmenge unabhängig von Schwankungen der gesamten Leukozytenzahl zeigt – ein wichtiger Unterschied, den viele Hausärzte in der Schweiz regelmässig erklären.
Wann müssen erhöhte Basophile unverzüglich hämatologisch abgeklärt werden?
Eine dringende Abklärung ist nötig, wenn die erhöhten Basophilen zusammen mit anderen Auffälligkeiten im Blutbild auftreten, etwa einer sehr hohen Gesamtleukozytenzahl (z. B. >20’000 /µl), einer Blutarmut, einem Mangel an Thrombozyten, unreifen Zellen im Blutausstrich oder Allgemeinsymptomen wie Nachtschweiss, Gewichtsverlust oder einer vergrösserten Milz.
Welche Untersuchungen sind bei einer Basophilie als Erstes sinnvoll?
Der erste, entscheidende Schritt ist die Kontrolle des Blutbilds mit einem manuellen Differentialblutbild zur Bestätigung des Befunds. Danach ordnen Schweizer Hämatologen meist, basierend auf Vorgeschichte und Symptomen, diese Basisuntersuchungen an: CRP und BSG (Entzündungswerte), TSH (Schilddrüsenfunktion) und Gesamt‑IgE (Allergie-Marker).
Bedeuten erhöhte Basophile immer eine Allergie oder Leukämie?
Nein, nicht zwangsläufig. Obwohl Allergien zu den häufigsten Gründen zählen und Leukämie die schwerwiegendste Möglichkeit darstellt, gibt es viele andere Ursachen wie eine Schilddrüsenunterfunktion, Autoimmunerkrankungen, chronische Entzündungen oder bestimmte Infektionen. Genau hier liegt die klinische Herausforderung: eine umfassende Differenzialdiagnostik ist entscheidend.
Ist bei einer isolierten, leicht erhöhten Basophilie eine Knochenmarkbiopsie erforderlich?
In der Regel nein. Ein einzelner, nur leicht erhöhter Basophilenwert (z. B. 2 % bei normaler Leukozytenzahl) ohne weitere Blutbildabweichungen und ohne besorgniserregende Symptome erfordert meist lediglich eine Verlaufskontrolle nach einigen Wochen oder Monaten. Die Indikation zur Biopsie wird in Schweizer Spitälern sehr gezielt gestellt.
Wie bereitet man sich optimal auf einen Termin beim Hämatologen vor?
Bringen Sie zum Konsultationstermin Ihre gesamte bisherige medizinische Dokumentation mit, insbesondere alle früheren Blutbefunde (möglichst von den letzten Jahren, um Trends zu erkennen). Bereiten Sie zudem eine Liste aller regelmässig eingenommenen Medikamente und Nahrungsergänzungsmittel vor und notieren Sie sich beunruhigende Symptome mit Zeitangabe des Beginns.
Autoritative Quellen
- Podwyższony i obniżony poziom bazocytów – Badania Krwi – Diese umfassende, nicht-kommerzielle Quelle bietet detaillierte Informationen zu Basophilen, inklusive ihrer Funktion, Referenzbereiche, Ursachen für erhöhte Werte und klinische Interpretation, was den Artikelinhalt ideal ergänzt.
- Bazocyty (bazofile) – funkcje, normy, podwyższone i obniżone bazocyty – Ein seriöses polnisches Gesundheitsportal mit medizinisch geprüften, vertiefenden Inhalten über Basophile, ihre biologische Rolle, Normwerte und Ursachen für Abweichungen, das fundierte Unterstützung für Leser bietet.
- Przewlekła białaczka szpikowa – badania – Eine autoritative polnische Hämatologie-Ressource ohne kommerzielles Interesse, welche klinische Leitlinien zur Diagnostik bei erhöhten Basophilen im Kontext der chronischen myeloischen Leukämie bereitstellt – hochrelevant für den klinischen Teil des Artikels.
- Bazofile we krwi – jak interpretować wyniki badania? – Ein etabliertes polnisches Labor-Netzwerk, das Bildungsinhalte zur Interpretation von Basophilen-Bluttests anbietet und damit den Fokus des Artikels auf Labornormen und klinischem Kontext unterstützt.
- Biopsja szpiku kostnego – czym jest, rodzaje, pobranie szpiku. – Onkopedia ist eine medizinisch autoritative polnische Wissensdatenbank für Onkologie, die detaillierte Informationen über Knochenmarkbiopsie-Verfahren, Indikationen und deren Relevanz für Blutkrankheiten liefert – entscheidend für die umfassende Abdeckung der hämatologischen Diagnostik bei erhöhten Basophilen.



